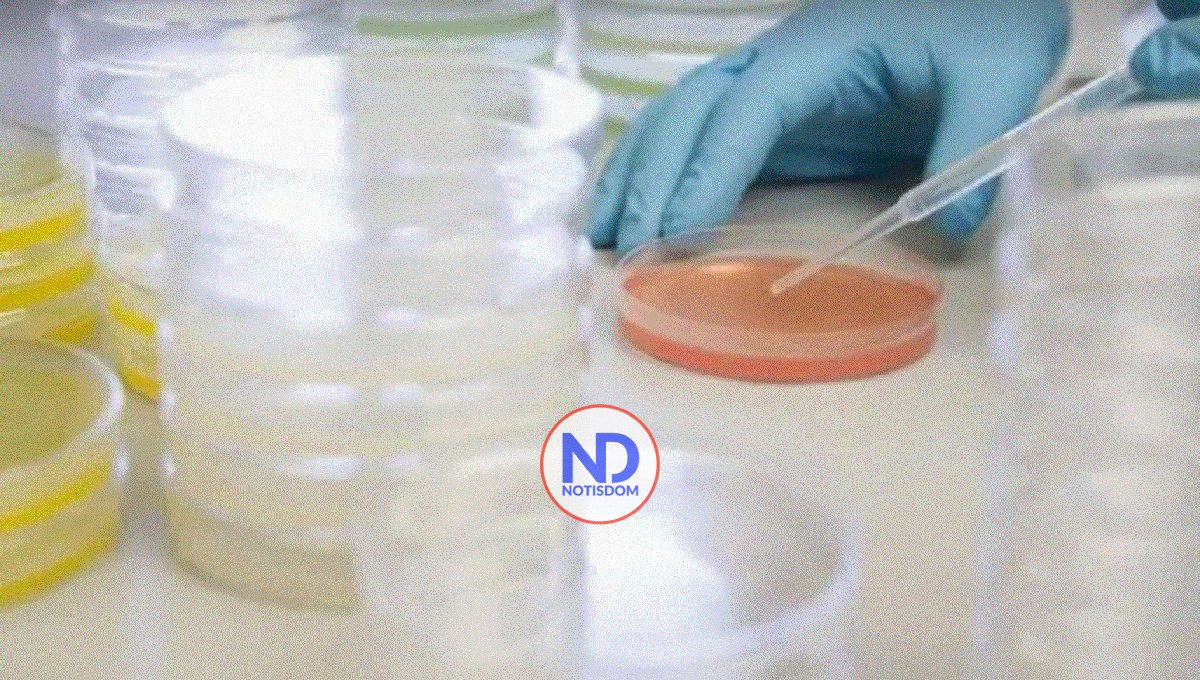
Autoridades confirman primer caso de cólera en Capotillo

Autoridades confirman primer caso de cólera en Capotillo
SANTO DOMINGO.- Tras la confirmación del primer caso de cólera en el sector de Capotillo del Distrito Nacional, genera preocupación entre los residentes de esa demarcación, quienes desde ya han empezado a tomar medidas preventivas.
La información la dio a conocer el Ministerio de Salud Pública la mañana de este jueves.
Al manifestar que el sistema de alcantarillado se encuentra colapsado, los moradores temen que con el primer contagio, la bacteria se propague por toda la zona.
